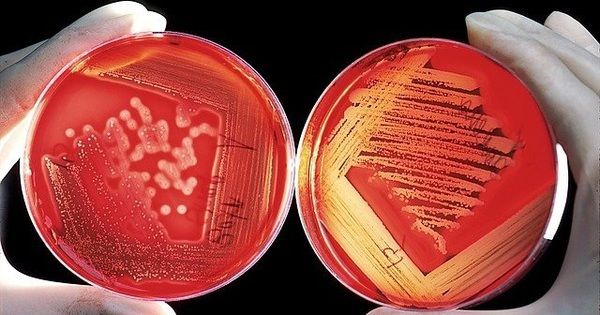
Tận hưởng cảm giác tự tin tuyệt đỉnh! 7 nguyên nhân gây mùi hôi vùng kín và bí quyết loại bỏ

Tổng hợp - Tag: Chăm sóc cá nhân
Bí quyết giữ vùng kín khỏe mạnh: Sử dụng 4 thực phẩm tuyệt vời này!
Nhắc đến phòng tránh viêm nhiễm vùng kín, vệ sinh hàng ngày là quan trọng Tuy nhiên, chị em cũng có thể sử dụng các thực phẩm hỗ trợ như: sữa chua không đường, tỏi, chanh, quả nam việt quất
Tận hưởng cảm giác tự tin tuyệt đỉnh! 7 nguyên nhân gây mùi hôi vùng kín và bí quyết loại bỏ
SKĐS - Mùi hôi vùng kín phụ nữ là điều bình thường, nhưng nếu không được điều trị đúng cách, nó có thể trở nên nghiêm trọng Bài viết này sẽ giúp bạn hiểu rõ nhóm nguyên nhân và cách khắc phục mùi âm đ...